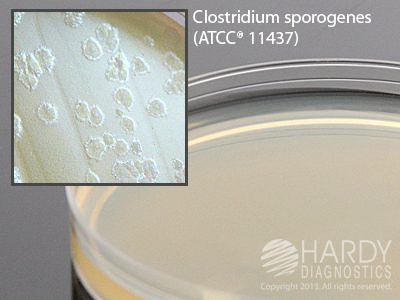
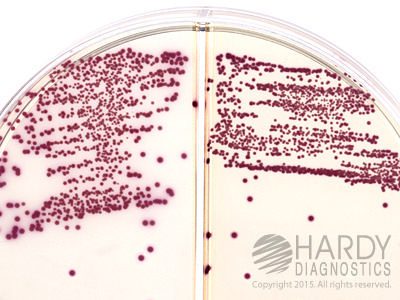

Bioreagents
Strep B Carrot Broth Tiles, Hardy Diagnostics – Z140T, Jar of 20 tiles, Strep B CarrotBroth Tiles
$14.28TILE STREP B CARROT BROTH 20 TILES/JAR
Standard Methods Agar (Plate Count Agar), Hardy Diagnostics – U297, Pack of 10, Standard Methods Agar
$251.75AGAR STANDARD METHOD 500 ML PC BOTTLE
HardyVal Tryptic Soy Broth, USP, Media-Bag, Hardy Diagnostics – U100, Tryptic Soy Broth (TSB), USP
$118.23TRYPTIC SOY BROTH USP AEROBIC BACT 100ML
EnviroTrans Swab Rinse Kit, Barney Miller Broth, Hardy Diagnostics – SRK100, Barney Miller Broth
$68.08KIT BARNEY MILLER BROTH ENVIROTRANS 5ML
Letheen Broth, Hardy Diagnostics – U371, Pack of 10, Letheen Broth
$219.40BROTH LETHEEN 1 L/1000 ML FILL PP BTL
Letheen Broth, Hardy Diagnostics – U471, Pack of 10, Letheen Broth
$139.28BROTH LETHEEN 500ML/400ML FILL PP BOTTLE
Egg Yolk Agar, Modified, Hardy Diagnostics – G215, Pack of 10, Egg Yolk Agar, Mod.
$102.40AGAR EGG YOLK MODIF 15X100 MM 18 ML FILL
Vancomycin Disks, Hardy Diagnostics – Z7501, 50 disks, Vancomycin Disks
$22.20VANCOMYCIN VA-5 5 MCG F/DIFF ANARB BACT
Blank Paper Disk for AST, Hardy Diagnostics – Z7121, 0.25 IN., Blank Disk
$16.97DISK BLANK PAPER 0.25IN DIAMETER FOR AST
SabHI Agar with Blood, Chloramphenicol and Cycloheximide HardyFlask, Hardy Diagnostics – X73, Pack of 20, SabHI Agar with Blood, Chloramphenicol and Cycloheximide HardyFlask
$87.25AGAR SABHI+Z2486 W/BLOOD 12ML HARDYFLASK
Lauryl Tryptose Broth, Hardy Diagnostics – K338, 10 mL, Double Strength
$109.95BROTH LAURYL TRYPTOSE W/MUG 2 STR 10 ML